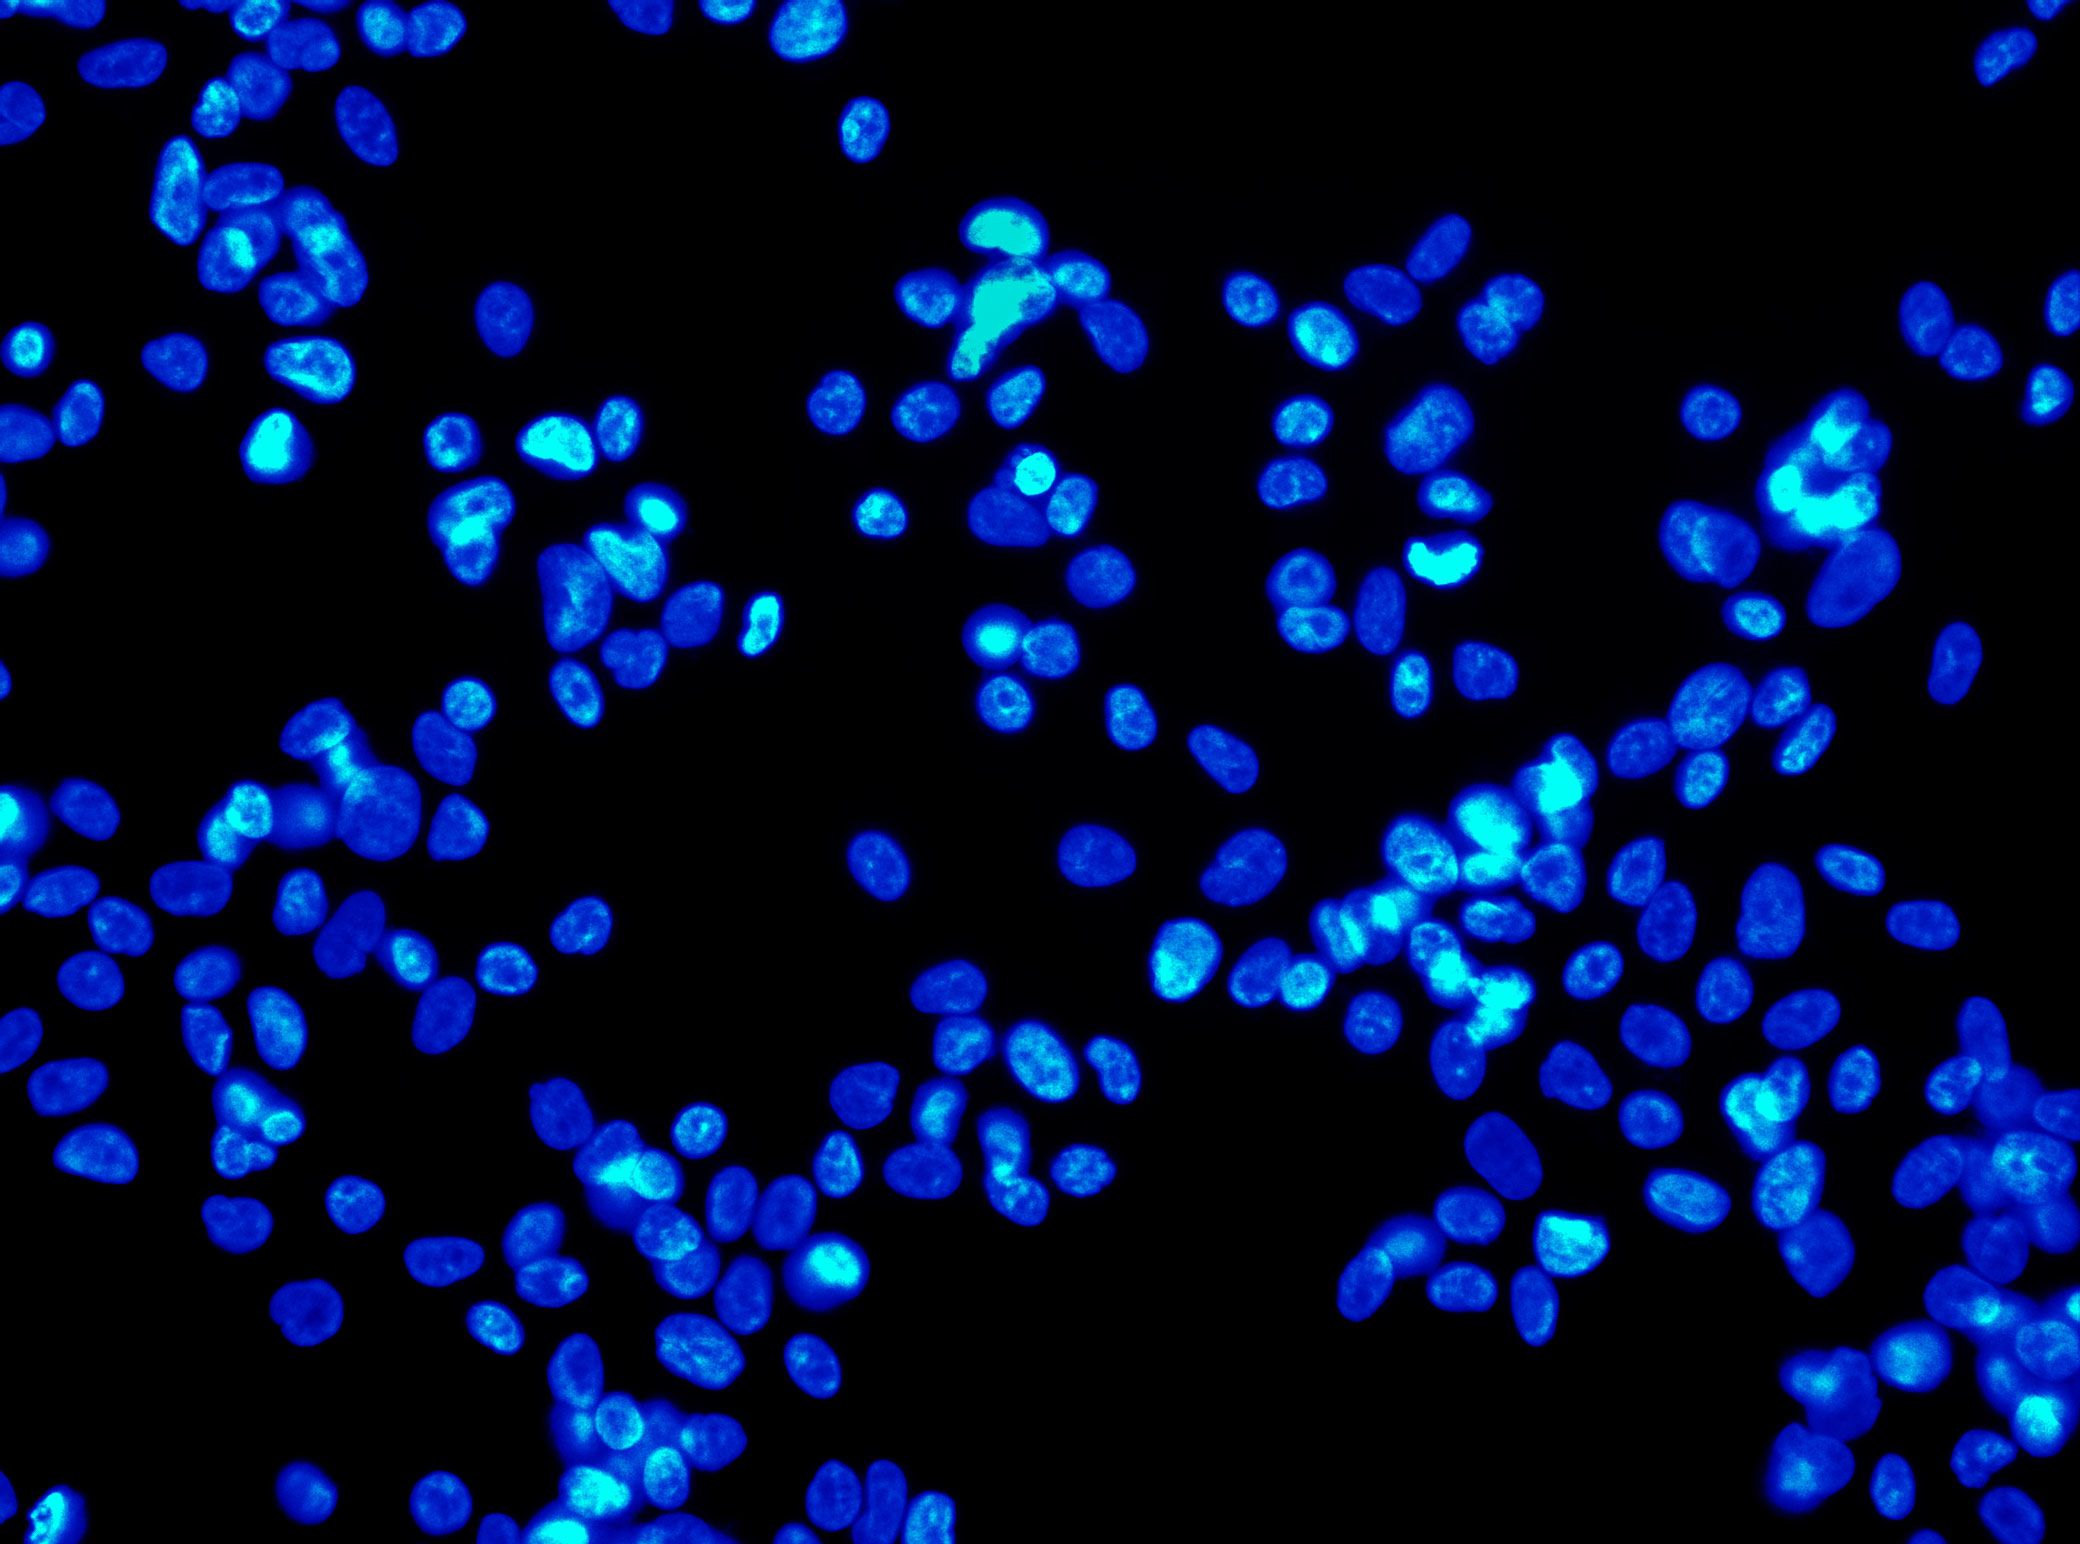

PLACE
MATTERS
MaRS is the world’s largest urban innovation hub, a place where today’s moonshots become tomorrow’s breakthroughs. It’s a launchpad for startups, a platform for researchers and a home to innovators.

WE HELP ENTREPRENEURIAL NETWORKS ADVANCE THE WORLD TOGETHER.

Where and how innovation happens is changing.
The flow of ideas is shifting from leafy suburban research parks towards vibrant, diverse downtowns. As boundaries between economic sectors collapse, entrepreneurs no longer have to stay in their lane. They borrow concepts from different fields, and repurpose and recombine them into something new.
MaRS was built on the insight that this new breed of innovators requires more than labs and offices.
They need a platform where they can meet, interact and collaborate with experts from related disciplines; a place to bounce ideas and co-create with others.
Only the density of an urban centre can bring about these creative collisions at the pace and scale required for today’s reality, where a chance encounter in a coffee shop can be as productive as a meeting in a conference room.
BUILDING FULL.
POTENTIAL UNLIMITED.

When MaRS opened in 2005 this concept of urban innovation was an untested theory.
Today, it’s reshaping cities around the world. MaRS has been at the forefront of a wave of change that extends from Melbourne to Amsterdam and runs through San Francisco, London, Medellín, Los Angeles, Paris and New York. These global cities are now striving to create what we have in Toronto: a dense innovation district that co-locates universities, startups, corporates and investors.
In this increasingly competitive landscape, scale matters more than ever – the best talent is attracted to the brightest innovation hotspots.
MaRS has adapted to maintain its lead. A decade after first opening its doors, MaRS completed construction of the long-awaited West Tower, doubling the size of the complex to become the world’s largest urban innovation hub. MaRS now provides 1.5 million square feet of flexible lab space, cutting-edge research facilities, and offices for corporates, startups and venture capitalists in the heart of Toronto’s Discovery District.
More importantly, the West Tower has allowed us to grow our innovation community. With the West Tower now full, MaRS is home to more than 150 organizations and draws over 6,000 people to work here every day.
Our carefully curated mix of tenants brings together global tech leaders like Facebook, Autodesk and PayPal with scientists from the University of Toronto and the Ontario Institute for Cancer Research. They work alongside high-growth companies like League and Highland Therapeutics, and startups in Johnson & Johnson’s JLABS accelerator. By 2018, MaRS will also host the Vector Institute for Artificial Intelligence and BlueRock Therapeutics, a new venture in regenerative medicine (see later).
WE CONNECT PEOPLE FROM MANY FIELDS AND EVERY PLACE – ACROSS SECTORS AND SPECIALIZATIONS.


The journey to build the West Tower was long and, at times, fraught. But the completed building is a statement of confidence in Toronto’s maturing innovation ecosystem and an investment in MaRS as a driver of future prosperity and economic growth.
Spurred by exceptionally strong demand for space from tenants, at the end of 2016 MaRS closed a refinancing deal with Canadian investment firms that has allowed us to repay the majority of an interest-bearing loan that the province of Ontario extended to us to complete the project. We have returned $290 million to the province three years ahead of schedule.
This private refinancing deal puts MaRS on a solid footing for decades to come, with a clear path to financial sustainability.
Photo: Ilse Treurnicht, former CEO of MaRS; Credit: Steph Martyniuk

The completion of the West Tower marks a new and exciting phase for MaRS. But the past year also saw the page turn on another chapter of the MaRS story. After more than 12 years guiding MaRS, and taking it from a blank canvas to one of the world’s leading innovation centres, Ilse Treurnicht stepped down as CEO in October 2017.
After a year-long search for her replacement, which considered candidates from both Canada and the international innovation community, Yung Wu was named MaRS’ new CEO. Yung is a pioneering entrepreneur and serial investor with a track record of founding and scaling groundbreaking startups. Under his leadership, MaRS will continue to work across its four key sectors – health, work & learning, energy & environment, and finance & commerce – to build global companies that can change the world.
Photo: Yung Wu, CEO of MaRS.
Moving to MaRS is an opportunity for us to influence the growing ecosystem of innovation – and be influenced by it. Our goal is to show what is possible with emerging technologies, like artificial intelligence, and build solutions to the world’s epic challenges.
Gordon Kurtenbach, Head of Research, Autodesk


MaRS today is a reflection of Ilse’s vision and unshakable belief that collaborative innovation will provide solutions to society’s problems.
Gordon Nixon
Chair, MaRS Board


Artificial intelligence is poised to become the growth story of the next decade, as smart machines take on complex analytical and decision-making functions. Toronto has been instrumental in developing these technologies: Geoffrey Hinton, the so-called “Godfather of AI,” created the field with his pioneering work on neural networks at the University of Toronto. This year, Toronto reasserted itself as a leading centre for AI research with the creation of the Vector Institute.
This $170-million initiative, co-founded by government and industry, will be located in the MaRS West Tower. It will help create a world-leading supercluster of AI research facilities and companies in downtown Toronto, and will train more graduate students in advanced computing than anywhere else.
The MaRS ecosystem, which already includes dozens of ventures that are using AI and machine learning such as Deep Genomics, is also drawing new organizations. These include:
- Uber’s first non-U.S. research facility for self-driving cars
- Borealis AI, RBC’s academic research institute focused on machine learning
- Element AI, an incubator for AI startups
- The Canadian Institute for Advanced Research (CIFAR), which is leading the implementation of the federal government’s AI strategy
This activity is attracting global attention – and talent. In-demand experts and researchers are now moving or returning to Toronto in unprecedented numbers, creating a powerful new economic driver.

Advances in stem cell therapies are transforming healthcare, broadening the focus from treating diseases to regenerating tissues and organs. As home to two major stem cell research and commercialization organizations (CCRM and the McEwen Centre), MaRS is already a focal point for regenerative medicine.
That status was enhanced when Bayer and Versant Ventures selected MaRS to house the research and manufacturing facilities for their new joint venture, BlueRock Therapeutics. BlueRock will collaborate with CCRM and the McEwen Centre to commercialize stem cell treatments for serious brain and heart diseases. It was funded with a US$225-million investment from Bayer and Versant – the second-largest biotech investment in history – and will employ a team of 50 in Toronto.
The addition of BlueRock as a MaRS tenant creates an almost unrivalled concentration of stem cell research and commercialization expertise combined with advanced technical and manufacturing facilities.

Everyone who joins a startup has moments when they wonder if they’ve done the right thing. The odds seem so stacked against you. But nothing compares to the exhilaration of launching a product and seeing people using it for the first time.
Eva Wong
Co-Founder and COO, Borrowell


MaRS Venture Services accelerates the growth of more than 1,000 young companies whose technologies and solutions can meaningfully improve lives.
This year, MaRS refocused its venture services to meet demand for individualized support from the growing number of later-stage companies in Toronto's maturing startup ecosystem.
Our venture services offering is now organized into three streams that connect entrepreneurs to the skills, capital, talent and customers needed at each stage of their company's development. These are:
- Start. Advises startup ventures on generating early revenue, attracting seed-stage capital and building a strong team.
- Growth. Helps emerging ventures with revenue growth, new customer acquisition, talent recruitment and support raising Series A capital.
- Scale. Offers tailored services for ventures with more than $5 million in annual revenues, accelerating their revenue growth through connections to capital, talent and customer networks.
MaRS has also partnered with the provincial government, as well as Communitech and Invest Ottawa, to deliver the Ontario Scale-Up Voucher Program, which provides funding and expert advice to help innovative companies grow globally. Launched in September 2017, in the first two months, nine companies benefited from the program.

Notable recent funding rounds for ventures in the MaRS network include:
- Intellijoint Surgical - $11 million
- Newtopia - US$10 million ($12.5 million Cdn)
- Borrowell - $57 million
- League - US$25 million ($31 million Cdn)
- ecobee - $35 million
- Lendified - $24 million
- Transpod - $20 million
- Wealthsimple - US$37 million ($46 million Cdn)
- Dream Payments - $10 million
- Financeit - US$17 million ($21 million Cdn)
- Sensibill - $17.3 million
Entrepreneurship Education
MaRS is a leading provider of knowledge and insights for the next generation of entrepreneurs who will build tomorrow’s job-creating startups. We have redesigned our entrepreneurship programs, moving more content online to make it accessible to a broader community of innovators.
- In 2016, our online entrepreneurship resources were downloaded more than 2.7 million times and instructional videos were viewed 288,000 times.
- We delivered 198 workshops across the ONE Network, serving 2,780 entrepreneurs.




I was a clinician in Toronto when SARS unexpectedly hit the city, and I realized that we need better ways to predict the global spread of dangerous diseases. Today, we are using big data to track outbreaks around the world in real time.
Kamran Khan
Founder, BlueDot


MaRS develops programs that look beyond the immediate to see the possible: an innovative economy that works for all. We call this our “systems change” work because it deals with complex problems that require broad-based solutions. By pushing against systemic inertia and challenging regulations that haven’t kept pace with change, it clears a path for new ideas and technologies to reach markets and improve lives.
This work is not easy, but it is vital. As a trusted neutral party with deep networks in the public, private and non-profit spheres, MaRS is uniquely positioned to bring together the necessary stakeholders to drive change.
Recently, there have been a number of notable successes:
MaRS Centre for Impact Investing
MaRS took a major step toward opening new funding streams for non-profits and creating a more outcomes-oriented health system. The CII partnered with the Heart and Stroke Foundation, Public Health Agency of Canada and 11 private investors to launch Canada’s first social impact bond in health. The bond will pay for a program to prevent hypertension and will generate a financial return for its investors based on how well the intervention performs.
MaRS EXCITE
Using a unique collaborative model, MaRS EXCITE helps health innovators navigate lengthy regulatory and reimbursement processes, enabling them to get their products to patients and generate revenues faster. Bresotec became the first company to complete the program when its BresoDX at-home sleep apnea testing device was recommended to the Ontario Ministry of Health and Long-Term Care for adoption and roll-out to Ontario patients.
MaRS Solutions Lab
After publishing a high-profile report on the sharing economy, MaRS Solutions Lab became the go-to source for policymakers in Canada and beyond who are grappling with the implications of services like Uber and Airbnb. The report’s influence was also evident in a new regulatory framework for short-term rentals proposed by the City of Toronto.
Studio Y
MaRS partnered with the federal government on the Student Work-Integrated Learning program, a summer work experience and skills development program for post-secondary students across Canada. Over three years, it will provide 400 students with the skills and mindsets needed to thrive in the new economy.
Advanced Energy Centre
The Advanced Energy Centre has been engaged by Celsia, a Colombian renewable energy company, to provide advice on technological transformation in the sector, particularly blockchain-enabled solutions for the electricity sector and energy storage opportunities. Through this work, the AEC highlighted Canadian energy storage technologies, which Celsia is now evaluating for purchase.
Early on, I met an investor who said he’d be honest with me: the ratio of women-owned companies that get funded is very small. I didn’t think of myself as a female founder until people pointed it out.
Stephany Lapierre
Founder, tealbook


Canada is attracting global attention, and investment dollars are flowing in record amounts. In 2016, venture capital investment in Toronto rose by 10 per cent year-over-year. But increasing the pool of capital available to grow high-potential ventures still remains a priority.
MaRS connects ventures with an extensive network of investors locally and internationally. In our building alone, venture capital firms such as Real Ventures and the federal government’s development bank, BDC, sit alongside some of the startups they are funding. MaRS also develops global partnerships that foster investment in Canadian ventures and we organize events such as RESI on MaRS, an annual life-sciences conference that brings international investors to Toronto in large numbers.
MaRS IAF is Ontario’s most active seed-stage investment fund; 72% of the companies it has invested in have raised follow-on funding. Status as of November 2017:
- 142 investments
- $62.4 million invested
- $765.7 million in follow-on capital leveraged
ArcTern Ventures invests in early-stage cleantech startups. Status as of November 2017:
- 10 investments
- $55 million invested
StandUp Ventures Fund is the first of its kind in Canada: a timely attempt to address the critical funding gap faced by women entrepreneurs. StandUp is a partnership between the Investment Accelerator Fund and BDC, and will make up to 20 investments in ventures with at least one female founder.
MaRS Catalyst Fund combines profit with purpose. It invests only in early-stage companies that are creating a well-defined social or environmental benefit. The $5-million fund began making investments in 2016 and, so far, has five companies in its portfolio.
SVX is an online platform that connects ethically-minded investors to social impact ventures and funds. Launched four years ago, it has now extended its reach to include retail as well as accredited investors.
I had to call myself ‘Jay’ because employers didn’t want people with foreign-sounding names. Artificial intelligence lets us screen candidates without those kinds of biases, making the job market fairer for everyone.
Jahanzaib Ansari
Co-Founder & CEO, Knockri


Recent global events have challenged core Canadian values, such as multiculturalism and gender equality.
At a time when borders are tightening and horizons narrowing, MaRS has reaffirmed its commitment to fostering inclusive innovation – a proven factor in building successful companies. MaRS executives have spoken out in the international press, authoring articles in major outlets, including Time and Fortune. Locally, MaRS is creating an inclusion council to foster diversity within our organization and broader community, and participated in producing a landmark report on gender diversity in Canadian tech with #movethedial and PwC.
MaRS continues to be at the forefront of efforts to attract and support the best and brightest researchers and entrepreneurs. We are now a referral partner for the federal government’s new Global Talent Stream program, which expedites immigration for highly skilled tech workers. The program launched in June 2017 and MaRS helped four ventures hire through the Global Talent Stream in its first three months.



One quarter of the world’s population can’t access reliable electricity. It’s rewarding to know our off-grid renewable energy systems are powering lights and communications technologies where they’re needed most.
Miriam Tuerk
Co-founder & CEO, Clear Blue Technologies


Toronto has emerged as a global force – and MaRS is at the forefront.
The global political landscape, combined with a string of positive developments in Toronto, have ignited growing international interest in the city’s entrepreneurial ecosystem. MaRS has leveraged this interest to share Canada’s unique innovation story in major publications, including the New York Times, Wall Street Journal, Bloomberg, NPR, Fast Company and Forbes. MaRS has also partnered with VICE, a global media brand, on a video series that introduces our ventures to international audiences.
MaRS continues to welcome hundreds of international delegations annually and also forges international collaborations that help open export markets for Canadian ventures. This year alone, MaRS has signed partnerships in Japan, South America, India and Europe that are helping MaRS-supported ventures win customers. In November 2017, we opened a new space in New York in partnership with Grand Central Tech to provide Canadian entrepreneurs with a base to connect with global customers and investors.

Canada is having a moment, and we need to seize it. MaRS is the platform that will help our companies win — not just compete — on the global stage.
Yung Wu
CEO, MaRS

101 College Street
Toronto, Ontario, Canada
M5G 1L7
T: 416 673 8100
F: 416 673 8181
marsdd.com


